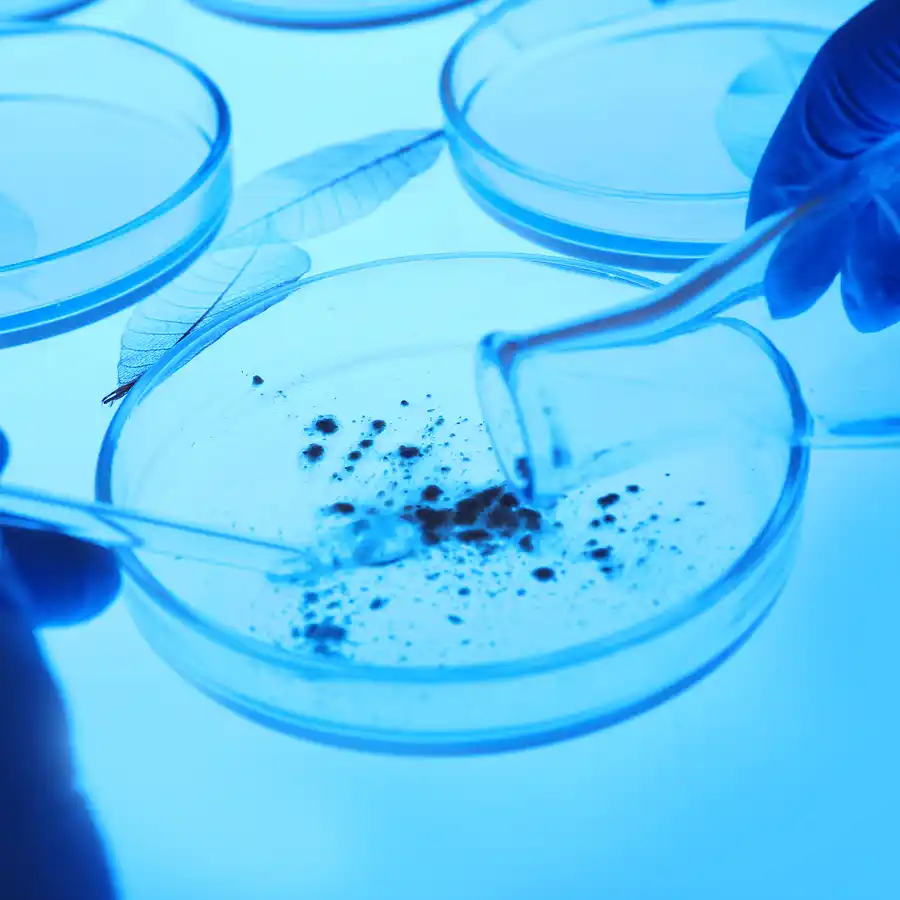
ESPERMOCULTIVO (CULTIVO DEL SEMEN)

Somos distribuidores en México del:
Si necesitas ver la información completa de los donantes, visita: European Sperm Bank
Los laboratorios Láfer, Con experiencia desde 2008 ayudando a muchas parejas a tener bebés sanos; Somos especialistas en Fertilidad Masculina contamos con catálogo de donantesde de semen nacionales e internacionales y banco de semen.
Banco de Semen y Laboratorio de Fertilidad Masculina
Fertilidad masculina

El análisis de semen es un estudio de gran importancia para conocer la fertilidad del hombre. De acuerdo a la última publicación del manual para el análisis de semen de la Organización Mundial de la Salud (OMS), este estudio se debe de realizar con metodologías estandarizadas y con un aceptable control de calidad.

Técnicas con la finalidad de mejorar la calidad del semen, obteniendo una cantidad óptima de espermatozoides con buena morfología y movilidad para inseminación artificial o fertilización in vitro.
Estudio que permite identificar agentes patógenos (bacterias, hongos) que causan infección e infertilidad.

Técnica publicada por el Dr. Ronald Ericson en 1973, basada en el uso de gradientes de albúmina humana para separar espermatozoides.

Evalúa el daño en el ADN de los espermatozoides. Es crucial en casos de infertilidad inexplicable.

La Hibridación in situ Fluorescente (FISH) es una técnica citogenética que evalúa alteraciones cromosómicas en espermatozoides.

Detecta faltas de secciones en el cromosoma Y que causan infertilidad masculina.

Análisis de tejido testicular o punción del epidídimo para encontrar espermatozoides vivos en casos de azoospermia.

Prueba genética que analiza el número, tamaño y estructura de los 46 cromosomas a partir de una muestra de sangre.

Estudio para buscar espermatozoides en la orina en casos de eyaculación retrógrada (cuando el semen ingresa a la vejiga).

Evaluación detallada de las características morfológicas de los espermatozoides.

La fructosa es un azúcar producida por las vesículas seminales y nutre a los espermatozoides.


Se obtiene muestra de semen de la cavidad vaginal y cérvix 9-12 horas después del coito, cerca de la ovulación.

Detecta la presencia de anticuerpos (IgA e IgG) contra espermatozoides en el semen.
En LÁFER hemos ayudado a que muchas parejas tengan bebes sanos. Nos dará gusto ayudarte y guiarte en este proceso de selección de tu muestra de donante. Sabemos que la calidad y exactitud de los resultados son muy importantes, pero también priorizamos tus emociones y sentimientos.
LÁFER también cuenta con una licencia sanitaria expedida por la Comisión Federal para la Protección contra Riesgos Sanitarios (COFEPRIS) para funcionar como banco de semen.